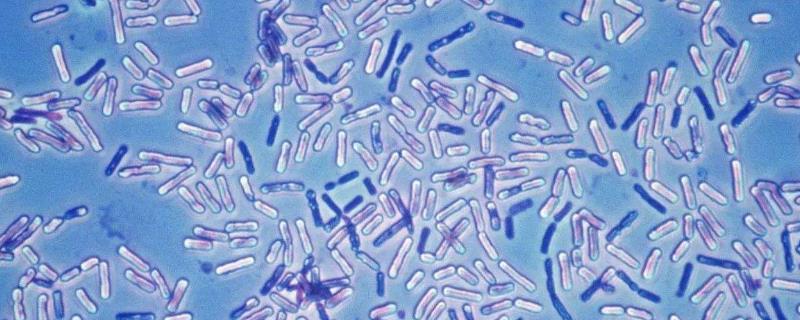
国外牛身上为什么要开洞,牛肚子上开洞放气牛不感染吗

如果你去到畜牧场,有可能看到以下这个场景,身上有着黑白花纹的牛吃着草摆动着尾巴,但它的腹部却有着一个奇怪的洞,畜牧场的工作人员可能还会带着手套,把手伸进牛腹部的洞里掏。
牛为什么身上会开一个洞?人又为何经常伸手进去掏?这难道是在虐待动物吗?

人类在牛的身上开了一个洞
人类养牛史
人类很早之前就开始养牛了。我国作为一个有着悠长历史的大国,自然很早就开始训牛。从出土的*物文**中发现,我国最早在 新石器时代 早期就开始养牛了。 在山东大汶口遗址和浙江河姆渡遗址都发现作为家畜的黄牛骨骼和水牛头骨。
在这一时期,牛多用来 供人类食用、祭祀 。据甲骨文记载,商王曾用 400头牛 来祭祀。而当时用于占卜的物品,则是牛的 肩胛骨 。

古人会用牛肩胛骨来占卜
再后来,牛用来耕作。据历史学家推断,最早在 春秋战国时期 开始用牛耕地并推广。因为当时出现了许多与牛相关的名字,比如孔子的徒弟 司马耕 ,他字伯牛,而晋国的一名力士也取名叫牛子耕。
并且,考古学家们也在 殷墟出土的甲骨文字 中发现了“耕”字, 甲骨象形文字中的耕很像牛仔犁沟中留下的蹄印。
牛是人类重要的食物,牛肉的蛋白质含量很高,并且富含大量的蛋白质、维生素,可增强人类的免疫力。 牛耕也是人类的重要农作方式,有牛的存在,大大的提高了人类的耕作效率并节省了人力。

中国具有悠久的牛耕文化
牛的消化系统
既然牛已和人打了上千年的交道,对人类帮助颇为巨大,人自然不可能无缘无故地去害它。要说为什么要在牛身上开个洞之前,我们得先讲清楚 牛的消化系统。
饲养的牛因为吃的都是饲草和饲料这些难以消化的粗纤维,所以牛一般是 反刍采食 。即 牛会在进食后的一段时间,把半消化的食物再返回到嘴里再次咀嚼后又消化一次。
牛的消化系统由 口腔、咽、食管、胃、小肠、大肠和肛门 组成。牛的口腔的作用自不必多说,用来咀嚼食物,吃一些磨碎的饲草和饲料, 而牛的咽在消化系统中成了吞咽食物的一个通道而后,嚼碎的食物通过食管肌肉的蠕动,进入到牛的胃中。

牛的反刍规律
牛的胃很神奇,它有四个。第一个胃叫 瘤胃 。瘤胃大部分位于腹腔的左边, 是反刍动物特有的消化器官 。瘤胃对纤维物质有着非常强的降解能力,吃下去的饲料和饲草大部分就是在瘤胃被消化掉了。
瘤胃中有许多 细菌、真菌以及微生物 ,这让它成了一个很好的发酵罐,在牛经过反刍把食物磨碎后, 瘤胃里的这些细菌、真菌微生物会把这些食物转化为菌体蛋白 。
菌体蛋白所含营养物质丰富,比 大豆、肉、鱼、奶 中的蛋白质含量都高。这些菌体蛋白随后会被牛吸收,让牛更加强壮。

牛胃模式图
网胃是食物进入牛胃后的第二站,它位于瘤胃前部 ,主要作用是筛出牛不能消化的一些硬物,比如没有经过磨碎的颗粒饲料,或者牛在进食过程中误食的一些石子、钉子。
接着,食物来到了位于牛腹腔右部的 瓣胃 ,瓣胃可以把食物残留的粗糙部分给磨得更碎,并吸收食物中的大量水分和酸。
在最后,食物到了 皱胃 ,皱胃能吸收食物中的部分蛋白,同时它也是牛的四个胃中唯一一个可分泌消化酶的胃。在经历这一轮过程后,食物将进入牛的小肠。

牛的内部结构图
牛的小肠分三段,十二指肠、空肠和回肠 ,食物在小肠中残留的时间较长,一般可达到7天左右。这时,小肠可以吸收营养物质,比如牛体必须的蛋白质、脂肪和糖分。随后食物来到牛的大肠。
为什么在牛身上开洞
在牛身上开的这个洞,其实是人给牛 造了一个瘘管 。 这个瘘管最早是用来治疗牛的疾病的。
在1822年,加拿大的一头牛被割草机器刮伤,伤口一直无法愈合。兽医便想了个办法, 他在牛的伤口部位开了一个洞,并在洞内套入一个套管,这样一来,伤口内的一些脓液便顺着洞口流了出来,牛最后也被治好了。 兽医给这项技术取了名字—— 造瘘术。
再后来,这项造瘘术被广泛传播。逐渐的,造瘘术也用于治疗牛常出现的一个问题,那就是胃病。

造瘘术治疗牛的胃病
因为牛吃的是草,又是反刍动物,饲草和饲料这种粗纤维的东西很容易导致牛消化不良和胃胀。
牛的瘤胃是一个容易出现胀气的地方。 瘤胃作为一个天然发酵罐,当牛吃掉大量容易发酵的草饲料的时候,这些草饲料会在牛的瘤胃里的微生物群的作用下产生大量的发酵气体,这些发酵气会使得牛胃胀。
而在牛胃中起承上启下作用的瓣胃,则因为它表面黏膜上有大小不等的叶瓣,在阻留大颗粒饲料时,会造成阻塞现象。
当瓣胃阻塞时,牛会变得没有食欲,并减缓反刍的速度,当情况变得严重时,瘤胃会完全停止蠕动,瓣胃与硬颗粒残留物接触,让牛疼痛无比,严重时会造成牛的死亡。

为牛清理胃里没有消化的饲料
所以,治疗牛的胃病,一直都是让兽医和养殖人员们头大的一个问题。在造瘘术出现之前,当牛消化不良时,为了治疗牛,都要用手从肛门把那些牛没有消化完的食物给掏出来,当造瘘术出现后,自然用不着这么原始的方式了。
一来牛也疼,二来兽医和养殖场的工人们也不愿再干这脏活了。 从开的瘘管出可以看到牛的消化情况,当牛胃胀气的也可以 直接从瘘管里把没有消化完的食物给掏出来。
在牛的腹部开个洞,牛当然会痛。牛又不是没有触觉神经的动物,特别是将手伸进瘘管里掏没消化好的食物时,牛的痛觉更胜。但相较于让牛因为胀气而死,开个洞就能让牛不那么容易受胃病的侵扰,而且,过去那种直接从肛门掏的方式更疼。

造瘘术能够解决牛胀气的问题
不过,是否要在牛身上造人造瘘管,也要视国家而定。
在中国,就基本没有这样的养殖方式, “瘘管牛”更多是出现在欧洲的养殖场 。而我国更多的是 让牛服用益生菌剂和药物 来进行治疗。
当牛的瘤胃因发酵过多发酵气而胀气时,我国的养殖户会在饲料里添加 枯草芽孢杆菌 ,枯草芽孢杆菌是一种 可以合成淀粉酶、蛋白酶、脂肪酶和纤维酶的活菌。
当它进入牛的皱胃后,可以协助皱胃的消化酶共同作用, 让牛能把残留在胃中的食物以比平时快三倍的速度消化掉,从而解决瘤胃胀气的问题。
枯草芽孢杆菌能促进食物消化
当牛的瓣胃因粗颗粒饲料过多而阻塞时,兽医们会往瓣胃里注射 含量5%的氯化钠注射液 来兴奋牛的肠胃蠕动,同时,还会给牛 喂食由石蜡油、硫酸镁或硫酸钠等和大量温水混合而成的药物 ,这种药物可以让牛缓泻,排泄掉阻塞在瓣胃里的粗颗粒饲料。
我国的大多养殖场,给牛喂食的饲料都是 不含泥沙的优质饲料 ,并给保证给牛充足的饮水。
大多数养殖场老板都有多年养殖牛的经验,并且有足够多的有关养殖方面的知识,自然也用不上给每一只牛都人造一个瘘管。

中国养牛场的牛基本不用造瘘术
人类的动物的索取
人类在牛的身上造瘘管,从某种意义上来说,还算是保护了牛,至少我们从瘘管中可以观察到牛是否消化不良,并 可简化对牛胃胀气的救治方式 ,必要的时候,牛身上的瘘管就是牛的救命药。
但人类对其他动物的索取,就是纯属于是对动物的伤害了。
比如 活取*胆熊** 。人类把金属管子的一端插进熊的胆囊,把另一端管子和玻璃瓶相连,通过这种方式把熊的胆汁给取出来。正因为熊的肚子上一直插有金属管,伤口不愈合,熊常常会因伤口感染而痛苦欲绝。

取*胆熊**汁
更残忍的是,为了增加*胆熊**汁的流出量,他们还会把特制的针扎进熊的胆囊里取胆汁。每当这个时候,被抽取胆汁的熊会疼得嗷叫,更有甚者会把自己的腹部抓得血肉模糊。
被抽取胆汁的黑熊一生都被关在一间小小的黑笼子里,这是为了防止熊活动和因为太过疼痛而自虐,被长期囚禁的熊伤口溃烂,腹部伤口被严重感染,有时还能看到褐色的脓水从溃烂的伤口流出。

被取胆汁的黑熊极为痛苦
*胆熊**一直在中医里是一味很高级的药材 ,中医说“*胆熊**明目”。而现在,我国已严厉禁止过去那种用金属管抽取胆汁的行为,而研究出了一种 无管引流 方式,这种方式只需十几秒就可让熊的胆汁流出而不影响到熊的自然活动。
鱼翅 ,因为蛋白质含量高,食材本身也够美味,一直都是高等宴席的餐桌上的一道美食。
但 鱼翅是鲨鱼的背鳍 ,为了吃鱼翅,很多渔民会捕捞鲨鱼,并割下它的背鳍,有时被割下背鳍的鲨鱼因为无用会再度被放回海里。失去了背鳍的鲨鱼在海中扑腾不了两下就会死去,可以说是十分残忍了。

鱼翅就是鲨鱼的背鳍
结语
人类站在食物链顶端已经有千年之久了。在这千年中,我们发展了 畜牧业、农业 ,很多动物都被我们驯化,有的能帮我们耕田,有的甚至成了我们的宠物。
在都市这个由冰冷的建筑构成的生活空间里,许多城市人都开始养猫养狗,把自己的孤独的情绪寄托在这些可爱的宠物上。

宠物能寄托人类情感
但是,正因为人类站在那么高的位置,所以一些时候我们虐待,消灭一种物种后都不自知。
现在,有许多生物因为人类的活动而遭到灭绝,就比如 渡渡鸟、北美白狼 ,更夸张的,曾在地球上拥有数亿只的 旅鸽 ,也因为人类的捕杀,不到一个世纪的时间就全部灭绝。